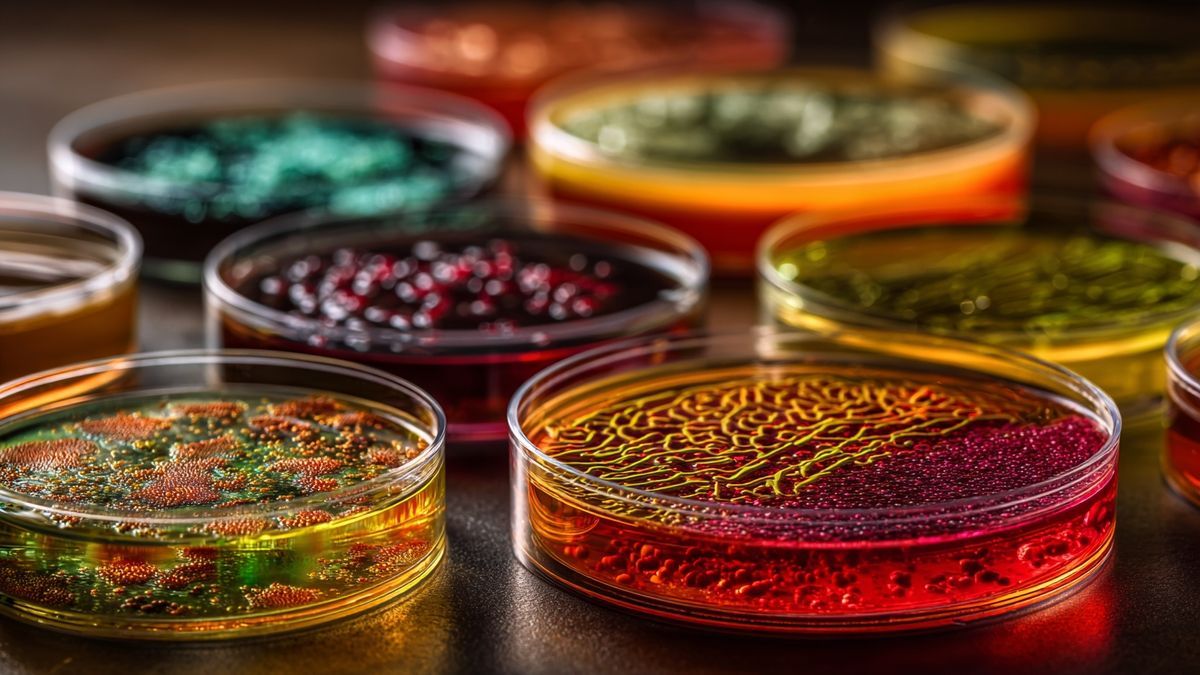
Transplantation de microbiote pour athlètes et fonction digestive

La médecine régénérative révolutionne le monde du sport en offrant des solutions novatrices pour la récupération des athlètes. En combinant des techniques avancées, telles que[…]

Les thérapies géniques révolutionnent le sport en offrant des solutions personnalisées pour optimiser les performances des athlètes. En alliant interventions génétiques et nutrition, ces approches[…]

Les essais randomisés contrôlés (RCT) représentent le pilier de la recherche en nutrition sportive. Ils permettent d’évaluer l’efficacité des interventions nutritionnelles avec précision. Grâce à[…]

L’interaction entre le microbiote intestinal et la performance sportive suscite un intérêt croissant. Des protocoles d’études rigoureux permettent d’explorer comment la composition microbienne influence l’endurance,[…]

La médecine personnalisée et la nutrition de précision transforment l’approche classique en santé sportive. En adaptant les stratégies de suivi et d’alimentation aux spécificités individuelles[…]

L’épigénétique joue un rôle fascinant dans la nutrition sportive, influençant l’expression génétique et la performance des athlètes. Les nutriments ne se contentent pas de nourrir[…]
La transplantation de microbiote fécal émerge comme une solution prometteuse pour optimiser les performances sportives. La compréhension de l’écosystème microbien révèle son rôle essentiel dans[…]

Les variables confondantes représentent un défi majeur dans les études de nutrition sportive. Leur impact sur l’interprétation des résultats peut fausser nos conclusions. Comprendre ces[…]

La recherche et la validation scientifique en nutrition sportive reposent sur des méthodologies rigoureuses. Une approche scientifique est essentielle pour garantir des résultats fiables et[…]

L’approche multi-omiques révolutionne la nutrition sportive en intégrant des données complexes sur les athlètes. En alliant génétique, protéomique et métabolomique, cette méthode ouvre la voie[…]